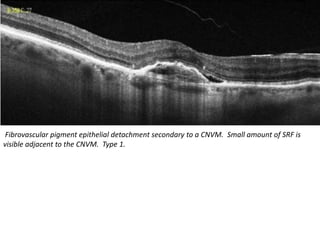
Fibrovascular pigment epithelial detachment secondary to a CNVM. Small amount of SRF is
visible adjacent to the CNVM. Type 1.

Choroidal neovascularization (CNV) involves the abnormal growth of new blood vessels from the choroid layer of the eye through Bruch's membrane. This can cause vision loss and is a common cause of wet macular degeneration. CNV occurs due to alterations in Bruch's membrane and high levels of vascular endothelial growth factor. It is classified based on its location relative to the retinal pigment epithelium and fovea. Symptoms include sudden vision loss and visual distortions. CNV is diagnosed through imaging like optical coherence tomography and fluorescein angiography and treated with injections of anti-VEGF drugs to inhibit blood vessel growth.